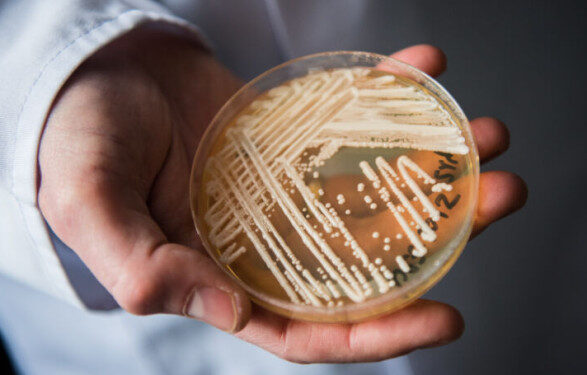
В США распространяется устойчивый к лекарствам потенциально смертельный грибок: его резистентность выросла на фоне COVID

КИЕВ. 21 марта. УНН. Исследователи из Центра контроля и профилактики заболеваний США сообщили, что смертоносный грибок Candida auris начал распространяться и получил еще большую устойчивость к лекарствам во время пандемии COVID-19. Его отнесли к категории «неотложной угрозы», пишет УНН со ссылкой на arsTechnica.
Цитата
«Быстрый рост и географическое распространение случаев вызывают беспокойство и подчеркивают необходимость постоянного наблюдения, расширения мощностей лаборатории, более быстрых диагностических тестов и соблюдения проверенных мер профилактики и контроля инфекций», — заявила ведущий автор исследования, эпидемиолог CDC Меган Лайман.
Детали
Отмечается, что Candida auris считаются «неотложной угрозой», что является самым высоким уровнем беспокойства CDC, с тех пор, как о них впервые было сообщено в США в 2016 году. Грибок скрывается в медицинских учреждениях и «охотится» на уязвимых пациентов, вызывая инвазивные инфекции со смертельным исходом от 30 до 60 процентов.
В 2019 году, до начала пандемии, 17 штатов и Вашингтон сообщили о 476 клинических случаях. В 2021-м грибок обнаружили в 28 штатах, а количество клинических случаев почти удвоилось до 1471. Бессимптомные случаи, выявленные во время скрининга пациентов, также подскочили на фоне пандемии, утроившись с 1310 случаев в 2020 году до 4041 случая в 2021-м, свидетельствуют данные Annals of Internal Medicine.
По словам исследователей, распространение Candida auris было не единственным тревожным аспектом эпидемии грибка. Он также стал более устойчивым к лекарствам. Следовательно, до пандемии было только четыре сообщения о панрезистентных инфекциях, то есть грибок был устойчив ко всем доступным препаратам. В 2021 году пациентов с панрезистентными инфекциями было семь.
До пандемии случаи резистентности к эхинокандинам и панрезистентности развивались независимо у пациентов во время длительного лечения, другими словами, это были отдельные случаи, которые не возникли путем передачи от человека к человеку. Но в 2021 году были доказательства двух вспышек эхинокандинорезистентных и панрезистентных штаммов с передачей от человека к человеку.
«Сроки этого усиленного распространения C. auris и результаты исследований в сфере здравоохранения свидетельствуют о том, что это могло усилиться связанным с пандемией напряжением системы здравоохранения», — подытожили Лайман и ее коллеги в исследовании.
Исследователи CDC подозревают, что причиной проблемы могла стать нехватка персонала и средств индивидуальной защиты, а также изменения в передвижении пациентов и увеличение использования антимикробных препаратов. Они также предположили, что в то время, как определенные меры контроля за инфекцией были усилены во время пандемии, другие, возможно, остались на обочине, например дезинфекция окружающей среды, которая могла усилить распространение. Они призвали к возобновлению усилий по ограничению передачи.
Напомним
Управление по санитарному надзору за качеством пищевых продуктов и медикаментов США (FDA) одобрило долгожданный новый препарат, предназначенный для замедления снижения когнитивных функций у пациентов с болезнью Альцгеймера.
ЧИТАЙТЕ ТАКЖЕ: Что такое стресс, кто меньше всего защищен от него и как с ним бороться – рассказывает эксперт